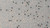
Fine Glitter Rubber Skirt Material
FG-203

Skirts Plus Bio-Flex Silicone Fine Glitter (FG Series) Skirt Tabs
Fine Glitter (FG Series) Silicone Skirt Material
Make your own custom jigs with our TMC Lures variety of Fine Glitter (FG Series) Silicone Skirt Material. The Fine Glitter Silicone Skirt Material can be used to make skirts for jigs, spinnerbaits and other lures. Some anglers even use partial pads as accent colors for various bass jigs and spinnerbaits. Cut off end tabs after you tie the skirt using our silicone skirt collars or thread. The possibilities are endless with silicone fishing lure skirt material. Skirts Plus Bio-Flex Fine Glitter Silicone Skirt Material is great if you prefer a more subtle look in color but you still want a hint of flash. The flake size of our fine glitter material is about 1/3 smaller in size than our standard glitter. Sold 10 skirt pads to a pack.
Whether you’re looking for standard material for jigs and spinnerbaits or thin cut material for finesse fishing or heavy durable muskie material, we’ve got it. With a wide array of colors and the most supple material ever made from the purest silicone rubber, Skirts Plus Rubber Skirt Material is the choice for the most discerning anglers. Add to the line-up a variety of rattle systems for jigs and spinnerbaits, and you’ll know why we are proud to invite you to the future of fishing, where “Innovation is our Reputation.”™
Shop Custom Bass Jigs & Jig Heads For Silicone Skirt Material
TMC Lures offers a variety of custom bass fishing jigs for the jig fisherman. TMC Lures custom bass fishing jigs are all hand-tied, the heads are finished using House of Kolor airbrush paints along with their rock a hard clear coat and all are equipped with a super sharp Gamakatsu hook. Whether your casting jigs for bass under docks, swimming jigs near brush or fishing football jigs on rocky bottoms, Taylor Man’s Custom Lures has the custom bass fishing jigs for you. Each bass jig has a carefully selected custom skirt pattern with colors to mimic natural prey.